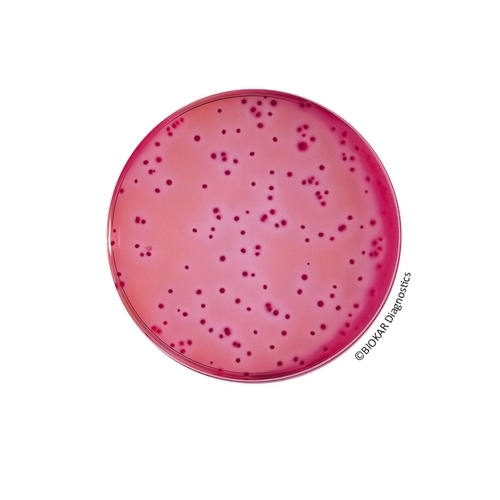
VRBL Agar

VRBL Agar
Violet Red Bile Agar (VRBL) is a selective medium used for the detection and enumeration of coliform and thermotolerant coliforms food products.
| Ürün Adı | VRBL Agar |
| Ürün Kodu | BM03408 |
| Miktar | 10 vials of 100 mL |
| Ürün Adı | VRBL Agar |
| Ürün Kodu | BM03508 |
| Miktar | 10 vials of 200 mL |
TECHNICAL DATA SHEET
TDS_VRBL AGAR_BK152_BM034_BM035_ENv7